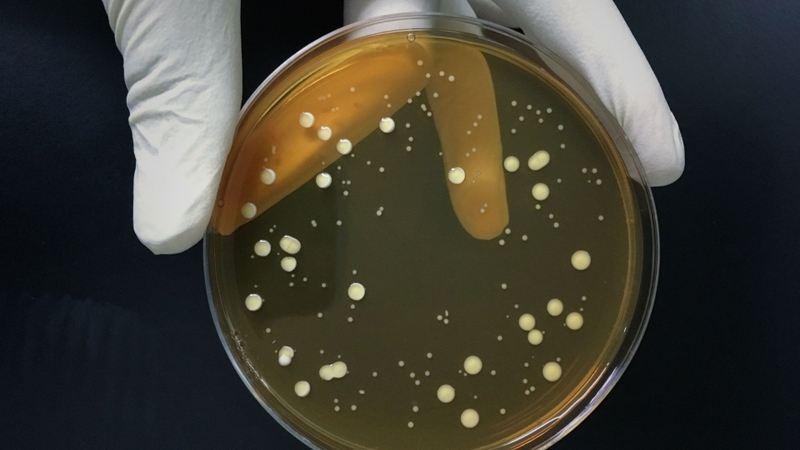
Pyrithione là hợp chất có hoạt tính sinh học mạnh, nổi bật với khả năng ức chế sự phát triển của vi sinh vật

- Tìm hiểu chung
- Liều dùng & cách dùng
- Ứng dụng
- Lưu ý
- Tìm hiểu chung
- Liều dùng & cách dùng
- Ứng dụng
- Lưu ý
Pyrithione là gì? Vai trò của Pyrithione đối với đời sống
31/01/2026
Mặc định
Lớn hơn
Pyrithione là một hợp chất kháng khuẩn và kháng nấm, thường được sử dụng dưới dạng zinc Pyrithione trong các sản phẩm trị gàu và viêm da tiết bã. Hoạt chất này giúp ức chế sự phát triển của nấm Malassezia, từ đó giảm ngứa, bong vảy và hỗ trợ kiểm soát gàu hiệu quả. Pyrithione đã bị hạn chế hoặc cấm sử dụng trong mỹ phẩm tại một số khu vực (như EU) do lo ngại về độ an toàn khi dùng kéo dài, cần tuân thủ quy định hiện hành.
- Tìm hiểu chung
- Liều dùng & cách dùng
- Ứng dụng
- Lưu ý
- Tìm hiểu chung
- Liều dùng & cách dùng
- Ứng dụng
- Lưu ý
Tìm hiểu chung
Pyrithione là gì?
Pyrithione là một hợp chất hữu cơ chứa lưu huỳnh, được biết đến rộng rãi nhờ đặc tính kháng khuẩn và kháng nấm mạnh. Trong thực tế ứng dụng, Pyrithione hiếm khi được dùng ở dạng tự do mà phổ biến nhất là muối kim loại của Pyrithione, đặc biệt là zinc Pyrithione. Chính dạng này đã tạo nên dấu ấn lớn trong y học da liễu và công nghiệp chăm sóc cá nhân, nhất là trong các sản phẩm điều trị gàu và viêm da tiết bã.
Về mặt hóa học, Pyrithione có cấu trúc cho phép nó gắn với ion kim loại và can thiệp vào hoạt động sống của vi sinh vật. Cơ chế tác dụng chính liên quan đến việc làm rối loạn vận chuyển ion qua màng tế bào, ức chế quá trình trao đổi chất và hô hấp của nấm, vi khuẩn. Nhờ đó, các vi sinh vật gây bệnh, đặc biệt là nấm men Malassezia trên da đầu, bị kìm hãm sự phát triển hoặc bị tiêu diệt.
Trong lĩnh vực y - dược và mỹ phẩm, Pyrithione (dưới dạng zinc Pyrithione) được sử dụng rộng rãi để kiểm soát gàu, giảm bong vảy, ngứa và viêm ở da đầu. Ngoài ra, hoạt chất này còn xuất hiện trong một số chế phẩm dùng ngoài da nhằm hỗ trợ điều trị viêm da tiết bã, vảy nến nhẹ hoặc các tình trạng da có liên quan đến vi sinh vật. Nhờ khả năng tác động trực tiếp lên căn nguyên vi sinh, Pyrithione được đánh giá cao về hiệu quả khi sử dụng đúng nồng độ và thời gian.
Không chỉ giới hạn trong mỹ phẩm và y học, Pyrithione còn được ứng dụng trong công nghiệp, đặc biệt là sơn, chất phủ và vật liệu chống bám bẩn sinh học. Trong các môi trường ẩm hoặc tiếp xúc với nước, Pyrithione giúp ngăn chặn sự phát triển của nấm mốc và vi khuẩn, từ đó kéo dài tuổi thọ vật liệu.
Tuy nhiên, cùng với hiệu quả là những lo ngại về độ an toàn. Các nghiên cứu cho thấy Pyrithione có thể gây ảnh hưởng đến tế bào nếu sử dụng không kiểm soát, đặc biệt khi dùng kéo dài hoặc ở nồng độ cao. Vì lý do này, nhiều cơ quan quản lý đã siết chặt hoặc cấm sử dụng Pyrithione trong mỹ phẩm, tiêu biểu là Liên minh châu Âu, nơi zinc Pyrithione không còn được phép dùng trong các sản phẩm chăm sóc cá nhân. Ở những quốc gia vẫn cho phép, Pyrithione phải tuân thủ giới hạn nồng độ nghiêm ngặt và chỉ dùng ngoài da.

Điều chế sản xuất Pyrithione
Về mặt nguyên tắc, Pyrithione được điều chế bằng phương pháp tổng hợp hóa học, áp dụng cả trong nghiên cứu phòng thí nghiệm và sản xuất công nghiệp. Quá trình tổng hợp xuất phát từ các tiền chất hữu cơ chứa nhân dị hợp pyridin, trong đó các phản ứng được thiết kế nhằm hình thành nhóm chức thiol và cấu trúc N-oxide đặc trưng. Mục tiêu của quá trình điều chế là tạo ra phân tử Pyrithione có khả năng tạo phức với ion kim loại và biểu hiện hoạt tính sinh học.
Trong giai đoạn tổng hợp, phản ứng hóa học tập trung vào việc hình thành khung pyridin-thiol N-oxide, đây là phần cấu trúc quyết định các đặc tính kháng khuẩn và kháng nấm của Pyrithione. Các điều kiện phản ứng như dung môi, nhiệt độ và thời gian được kiểm soát nghiêm ngặt nhằm đảm bảo phản ứng diễn ra theo hướng mong muốn, đồng thời hạn chế sự hình thành các sản phẩm phụ và tạp chất.
Pyrithione thu được ở dạng tự do thường không được sử dụng trực tiếp trong thực hành. Trong sản xuất, hợp chất này tiếp tục được chuyển hóa thành muối kim loại, phổ biến nhất là zinc Pyrithione, thông qua phản ứng phối trí với ion kẽm. Việc tạo muối giúp cải thiện độ ổn định hóa học, giảm tính phản ứng không mong muốn và tăng tính phù hợp cho các ứng dụng trong y - dược, mỹ phẩm và công nghiệp.
Sau khi tạo muối, sản phẩm được đưa qua các công đoạn tinh chế, bao gồm loại bỏ tạp chất, kết tinh và làm khô. Mục đích của giai đoạn này là đạt được độ tinh khiết đáp ứng các tiêu chuẩn chất lượng tương ứng với từng lĩnh vực sử dụng. Việc kiểm soát tạp chất, đặc biệt là kim loại nặng và dư lượng hóa chất, là yêu cầu bắt buộc trong suốt quá trình sản xuất.
Do Pyrithione là hoạt chất có hoạt tính sinh học mạnh, quá trình điều chế và sản xuất chỉ được thực hiện tại các cơ sở đạt chuẩn, tuân thủ nghiêm ngặt các quy định về an toàn hóa chất và bảo vệ môi trường. Các yêu cầu pháp lý ngày càng chặt chẽ, đặc biệt trong lĩnh vực mỹ phẩm, đã góp phần định hướng việc kiểm soát và sử dụng Pyrithione trong thực hành hiện nay.

Cơ chế hoạt động
Tác dụng ức chế nấm của zinc Pyrithione chủ yếu liên quan đến hiện tượng gia tăng tích lũy đồng nội bào. Hiện tượng này được ghi nhận thông qua sự thay đổi biểu hiện của các gen liên quan đến cân bằng đồng, với sự suy giảm hoạt tính của hệ thống hấp thu đồng và sự tăng nhẹ các cơ chế đáp ứng với stress đồng trong tế bào vi sinh vật. Sau khi vào môi trường sinh học, phức hợp zinc Pyrithione có thể phân ly, giải phóng phối tử Pyrithione, từ đó tạo phức với ion đồng ngoại bào sẵn có trong môi trường của sinh vật mục tiêu.
Trong vai trò là một ionophore, Pyrithione có khả năng tương tác với màng tế bào theo cơ chế không đặc hiệu, hỗ trợ vận chuyển đồng vượt qua màng plasma và các màng nội bào. Nhờ cơ chế này, đồng có thể xâm nhập vào các bào quan, bao gồm cả ty thể. Sự tích tụ đồng nội bào dẫn đến bất hoạt các protein chứa cụm sắt - lưu huỳnh (Fe - S), theo cơ chế tương tự như độc tính của đồng đã được mô tả ở vi khuẩn.
Sự suy giảm chức năng của các protein Fe - S gây rối loạn các quá trình chuyển hóa thiết yếu, từ đó làm ức chế hoạt động trao đổi chất và kìm hãm sự phát triển của nấm. Bên cạnh tác động lên đồng, zinc Pyrithione cũng được ghi nhận gây tăng nhẹ nồng độ kẽm nội bào, tuy nhiên đây không được xem là yếu tố chính quyết định hiệu quả kháng nấm của hợp chất này.
Công dụng
Pyrithione là một hợp chất có hoạt tính sinh học đáng kể, được biết đến chủ yếu nhờ khả năng ức chế sự phát triển của vi sinh vật. Tác dụng của Pyrithione liên quan đến việc làm rối loạn cân bằng ion kim loại nội bào, qua đó ảnh hưởng đến các quá trình chuyển hóa thiết yếu và làm suy giảm khả năng sinh trưởng của vi sinh vật, đặc biệt là nấm và một số vi khuẩn nhạy cảm.
Ngoài ra, Pyrithione có khả năng tương tác với màng tế bào, làm biến đổi tính thấm và chức năng của màng, từ đó gián tiếp ức chế hoạt động của các enzyme và protein quan trọng. Nhờ những đặc tính này, Pyrithione được xem là một hoạt chất hiệu quả trong kiểm soát vi sinh vật, tuy nhiên việc sử dụng cần được kiểm soát chặt chẽ do hoạt tính sinh học cao và các yêu cầu nghiêm ngặt về an toàn.
Liều dùng & cách dùng
Pyrithione được sử dụng ngoài da nhằm hỗ trợ kiểm soát gàu và viêm da tiết bã, với cách dùng thay đổi tùy theo dạng bào chế. Nhìn chung, chế phẩm được thoa trực tiếp lên vùng da hoặc da đầu bị ảnh hưởng, với tần suất từ 1 - 3 lần mỗi ngày hoặc ít nhất vài lần mỗi tuần, tùy mức độ tổn thương và chỉ định cụ thể. Khi sử dụng trên da đầu, cần làm ướt tóc hoặc da, thoa thuốc, tạo bọt và mát xa nhẹ nhàng trong vài phút để hoạt chất tiếp xúc đều, sau đó rửa sạch.
Đối với các chế phẩm lưu lại trên da như kem, lotion hoặc dung dịch xịt, thuốc được thoa hoặc xịt một lớp mỏng phủ đều vùng tổn thương, có thể mở rộng nhẹ sang vùng da lành xung quanh. Việc điều trị thường được duy trì thêm một thời gian sau khi triệu chứng cải thiện nhằm hạn chế nguy cơ tái phát.
Ở trẻ em, đặc biệt là trẻ nhỏ, liều lượng và tần suất sử dụng cần được cân nhắc thận trọng và tuân theo hướng dẫn của nhân viên y tế. Tránh để thuốc tiếp xúc với mắt, niêm mạc và không sử dụng kéo dài hoặc trên vùng da tổn thương rộng khi chưa có chỉ định chuyên môn.

Ứng dụng
Trong y học và dược phẩm
Trong lĩnh vực y học và dược phẩm, Pyrithione được ứng dụng trong các chế phẩm dùng ngoài da nhằm kiểm soát vi sinh vật gây bệnh, đặc biệt là nấm và vi khuẩn nhạy cảm. Hoạt chất này góp phần hỗ trợ điều trị gàu, viêm da tiết bã và một số tình trạng viêm da có liên quan đến vi sinh vật. Việc sử dụng Pyrithione trong y dược đòi hỏi kiểm soát chặt chẽ về nồng độ, thời gian dùng và đối tượng sử dụng nhằm đảm bảo hiệu quả điều trị đồng thời hạn chế nguy cơ tác dụng không mong muốn.
Trong mỹ phẩm
Pyrithione, chủ yếu dưới dạng zinc Pyrithione, từng được sử dụng rộng rãi trong các sản phẩm chăm sóc cá nhân nhờ khả năng kiểm soát nấm và vi khuẩn trên da. Hoạt chất này giúp giảm gàu, bong vảy và ngứa, đồng thời hỗ trợ kiểm soát các tình trạng da liên quan đến sự mất cân bằng vi sinh. Tuy nhiên, do lo ngại về độ an toàn khi sử dụng lâu dài, Pyrithione hiện đã bị hạn chế hoặc cấm trong mỹ phẩm tại một số khu vực, và việc sử dụng phải tuân thủ nghiêm ngặt các quy định pháp lý hiện hành.

Lưu ý
Các lưu ý khi sử dụng Pyrithione:
- Chỉ sử dụng Pyrithione theo đúng dạng bào chế và mục đích đã được khuyến cáo, chủ yếu là dùng ngoài da.
- Không dùng Pyrithione trên vùng da bị tổn thương rộng, trầy xước nặng hoặc viêm cấp nếu không có chỉ định của nhân viên y tế.
- Tránh để chế phẩm chứa Pyrithione tiếp xúc trực tiếp với mắt, miệng, niêm mạc và các vùng da nhạy cảm.
- Không sử dụng kéo dài hoặc lặp lại nhiều đợt liên tiếp khi chưa có hướng dẫn chuyên môn, do hoạt tính sinh học của Pyrithione tương đối mạnh.
- Cần tuân thủ nghiêm ngặt nồng độ và tần suất sử dụng được khuyến cáo cho từng chế phẩm cụ thể.
- Thận trọng khi dùng cho trẻ em, đặc biệt là trẻ nhỏ, liều lượng và thời gian sử dụng nên do bác sĩ hoặc dược sĩ quyết định.
- Ngừng sử dụng và theo dõi nếu xuất hiện các dấu hiệu kích ứng da như đỏ, rát, ngứa tăng lên hoặc bong tróc bất thường.
- Không phối hợp Pyrithione với các chế phẩm bôi ngoài da khác khi chưa được tư vấn, nhằm tránh nguy cơ kích ứng hoặc tương tác tại chỗ.
- Việc sử dụng Pyrithione phải tuân thủ các quy định pháp lý hiện hành, đặc biệt tại những khu vực đã hạn chế hoặc cấm hoạt chất này trong mỹ phẩm.
- Drugbank: https://go.drugbank.com/drugs/DB06815
- Pubchem: https://pubchem.ncbi.nlm.nih.gov/compound/Pyrithione#section=Mechanism-of-Action
- Targeted Delivery of Zinc Pyrithione to Skin Epithelia: https://pubmed.ncbi.nlm.nih.gov/34575891/
- Pyrithione: https://www.mayoclinic.org/drugs-supplements/pyrithione-topical-route/description/drg-20065722#drug-proper-use
- Zinc Pyrithione: A Topical Antimicrobial With Complex Pharmaceutics: https://www.jddonline.com/articles/zinc-pyrithione-a-topical-antimicrobial-with-complex-pharmaceutics-S1545961616P0140X/?
:format(webp)/Option_1_2_2d9677e5fd.png)
:format(webp)/Option_1_1_2a84e0cd00.png)
